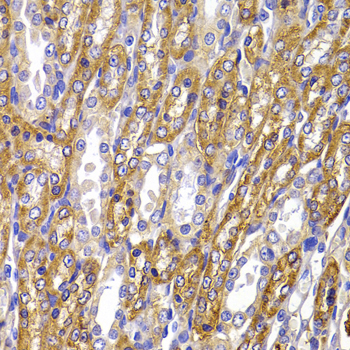
A7878: image 1

For quotations, please use our online quotation form, and you may also contact us by
sales@neoscientific.com
+1-888.733.6849
+1-617.299.7367 (Int’l)
+1-888.733.6849
+1-617.299.7367 (Int’l)
| Reactivity | Human Rat |
| Tested applications | WB IHC |
| Recommended Dilution | WB 1:500 - 1:2000 IHC 1:50 - 1:200 |
| Calculated MW | 113kDa |
| Observed MW | Refer to figures |
| Immunogen | A synthetic peptide of human ATP1A1 |
| Storage Buffer | Store at -20℃. Avoid freeze / thaw cycles. Buffer: PBS with 0.02% sodium azide, 50% glycerol, pH7.3. |
Immunohistochemistry of paraffin-embedded rat kidney using ATP1A1 antibody at dilution of 1:100 (x40 lens)..

Immunohistochemistry of paraffin-embedded human brain astrocytoma using ATP1A1 antibody at dilution of 1:100 (x40 lens)..

Immunohistochemistry of paraffin-embedded human prostate using ATP1A1 antibody at dilution of 1:100 (x40 lens).

Immunohistochemistry of paraffin-embedded human gastric using ATP1A1 antibody at dilution of 1:100 (x40 lens).
The protein encoded by this gene belongs to the family of P-type cation transport ATPases, and to the subfamily of Na+/K+ -ATPases. Na+/K+ -ATPase is an integral membrane protein responsible for establishing and maintaining the electrochemical gradients of Na and K ions across the plasma membrane. These gradients are essential for osmoregulation, for sodium-coupled transport of a variety of organic and inorganic molecules, and for electrical excitability of nerve and muscle. This enzyme is composed of two subunits, a large catalytic subunit (alpha) and a smaller glycoprotein subunit (beta). The catalytic subunit of Na+/K+ -ATPase is encoded by multiple genes. This gene encodes an alpha 1 subunit. Multiple transcript variants encoding different isoforms have been found for this gene.
N/A